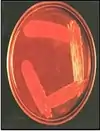

Кіоші Шига
Кіоші Шига (яп. 志賀 潔; його справжнє прізвище Сато, перше ім'я Наойосі; 7 лютого 1871, Сендай Ейдзі в Сендай-Каньйо / Сендай Кунімія Міягі-гарш, нині місто Сендай — 25 січня 1957) — японський лікар і бактеріолог, відомий описом першого представника роду Shigella.
| Кіоші Шига | |
|---|---|
| яп. 志賀潔 | |
![]() | |
| Народився |
7 лютого 1871[1] Сендай, Префектура Міяґі |
| Помер |
25 січня 1957[1] (85 років) Токіо-сітіd, Японія |
| Країна |
|
| Діяльність | лікар, біолог, викладач університету, бактеріолог |
| Alma mater | Токійський університет |
| Галузь | медицина |
| Заклад | Імператорський університет Кейдзьоd |
| Вчителі | Кітасато Сібасабуро |
| Членство | Леопольдина і Академія наук Японії |
| Нагороди |
|
Біографія
Ранні роки
Народився в Сендаї, префектура Міягі. У 1878 році його усиновила родина матері за прізвищем Шига, а його ім'я було змінено на Кіоші. Сім'я Шига займалася акупунктурою у Сендай-Кі. Закінчив медичну школу Токійського імператорського університету в 1896 році, пішов працювати в Бактеріологічний інститут до доктора Кітасато Сібасабуро.
Відкриття збудника шигельозу
Саме там Шига прославився відкриттям одного зі збудників бактеріальної дизентерії Shigella dysenteriae. Він це зробив у 1897 році під час тяжкої епідемії, в якій повідомлялося про понад 90 000 випадків, а рівень летальності досяг близько 30 %. Спочатку він опублікував своє спостереження японською мовою у Бактеріологічному часопису в рік епідемії, а наступного 1898 року повторив це в німецькомовному виданні[2]. Рід бактерій зрештою був названий його іменем, як й головний токсин, який виробляє Shigella dysenteriae.
Подальша кар'єра
У 1899 році став консультантом у Міністерстві внутрішніх справ та першим директором Інституту інфекційних хвороб.
З 1901 по 1905 рік Шига удосконалювався у Пауля Ерліха в Кайзеровському Прусському інституті експериментальної терапії в Берліні, де разом з вчителем встановив терапевтичний ефект анілінових (фуксин) і бензидинових (трипеновий синій і червоний) барвників при трипаносомозах. Після повернення до Японії відновив навчання інфекційним хворобам у Кітасато Сібасабуро. Повернувся до Японії і здобув науковий ступінь доктора медицини. Надалі вивчав авітаміноз бері-бері, встановив, що ця хвороба не є інфекційною. Також вивчав проказу.
1912 році знову виїхав до Німеччини та співпрацював там з Паулем Ерліхом.
Шига став професором університету Кейо в 1920 році.
З 1929 по 1931 рік Шига був президентом імператорського університету Кейджьо в Сеулі та був старшим медичним радником і керівником кабінету японського генерального губернатора Кореї.
У 1930 році після вступу на посаду президента університету прочитав тенденційну лекцію про історію та дослідження прокази, через що був звинувачений деякими професорами у неправомірних поняттях, через що подав у відставку наступного року, не пробувши термін на посаді. У цій лекції Шига сказав: «Перше полегшення прокази — це кастрація хворого, і це найефективніше у викоріненні її».
У 1931 році він повернувся до Японії і став радником Інституту Кітасато. Японською він опублікував двотомну працю про клінічну бактеріологію та інфекційні захворювання, а також про клінічну серологію.
У 1945 році повітряний наліт американської авіації на Токіо завдав йому збитків — він втратив все майно. З 1949 року він жив на віллі Кійоенсо селі Сакамото, префектура Міягі. Помер у 1957 році. Могила Шига розташована у Рінно-джі в Кітаямі, Аоба-ку, місті Айчі.

Визнання
Член Японської академії наук з 1948 року. Він був почесним членом британського Королівського товариства тропічних хвороб, асоційованим членом Інституту Пастера, спеціальним членом Німецької академії природничих наук (Леопольдина) і отримав почесне звання доктора Honoris causa Гарвардського університету.
Шига став кавалером ордена Культури в 1944 році. Також був нагороджений орденом Священного скарбу 1-го класу (Велика стрічка) посмертно в 1957 році.
Примітки
- Німецька національна бібліотека, Державна бібліотека в Берліні, Баварська державна бібліотека та ін. Record #143619829 // Німецька нормативна база даних — 2012—2016.
- Shiga K (1898), «Ueber den Erreger der Dysenterie in Japan», Zentralbl Bakteriol Mikrobiol Hyg, Vorläufige Mitteilung, 23: 599—600 (нім.)
Джерела
- Trofa AF, Ueno-Olsen H, Oiwa R, Yoshikawa M (1999), «Dr. Kiyoshi Shiga: discoverer of the dysentery bacillus», Clinical Infectious Diseases, 29 (5): 1303—1306, doi:10.1086/313437, PMID 10524979 (англ.)
- Whonamedit?- A dictionary of medical eponyms. Kiyoshi Shiga (англ.)
